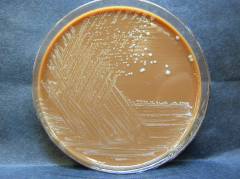

Интересные факты о туляремии
Возбудитель туляремии был впервые идентифицирован в 1911-1912 годах учеными Маккоем и Чепиным. Первоначальными носителями бактерии стали суслики. Официальные случаи туляремии зарегистрированы с начала XX века, однако исследования вспышек инфекционных заболеваний XIX века, таких как «доброкачественная чума» и «климатические бубоны», могут указывать на неправильно диагностированные случаи туляремии. Первый случай заражения человека в Северной Америке зафиксирован в 1910 году, а в Европе туляремия была диагностирована в Австрии в 1917 году.
В России заболевание выявлено в 1926-1928 годах в Рязанской, Тюменской и Воронежской областях. Перед началом Великой Отечественной войны туляремия стала угрожающим заболеванием, способным поразить значительное количество людей. В 1940 году в Советском Союзе зарегистрировано около 10 тысяч случаев заражения. Во время войны количество случаев значительно возросло. Советский исследователь Кен Алибек предположил, что вспышки инфекции были искусственными. Он отметил, что с 1941 по 1942 год случаи заражения увеличились в десять раз, а затем снизились. Примерно 70% заболевших поступали в военные госпитали с легочной формой болезни, что может свидетельствовать о намеренном распространении инфекции. По свидетельствам очевидцев, солдаты заражались туляремией от мышей.
Первая версия биологического оружия на основе возбудителя туляремии была разработана в 1941 году. Испытания проходили во время битвы под Сталинградом. Летом 1942 года среди немецких солдат зафиксировано множество случаев заражения туляремией, что привело к приостановке их наступления. Спустя неделю зараженные грызуны проникли на территории, контролируемые советской армией, и инфекция начала стремительно распространяться среди советских солдат и гражданских лиц. Мыши заражали продукты питания и воду, что вызвало многочисленные случаи инфицирования, два из которых закончились летальным исходом. Для борьбы с вспышкой инфекции в зону боевых действий направили 10 передвижных госпиталей.
Разработка биологического оружия продолжалась и в послевоенные годы. В 1980-х годах организовано массовое производство ракет с боеголовками, содержащими бактерии туляремии.
Врачи отмечают, что туляремия — это инфекционное заболевание, вызываемое бактерией Francisella tularensis. Основными причинами заражения являются контакт с инфицированными животными, укус насекомых или употребление contaminated пищи и воды. Симптомы могут варьироваться, но чаще всего проявляются в виде лихорадки, головной боли, усталости и воспаления лимфатических узлов. Важно отметить, что диагностика туляремии может быть затруднена из-за схожести симптомов с другими инфекциями. Для подтверждения диагноза врачи используют серологические тесты и микробиологические исследования. Лечение включает антибиотики, такие как стрептомицин или доксициклин, и при раннем обращении к врачу прогноз обычно благоприятный. Специалисты подчеркивают важность профилактических мер, таких как соблюдение гигиенических норм и использование средств защиты при работе с потенциально зараженными животными.

Возбудитель туляремии
Возбудителем туляремии является бактерия Francisella tularensis. Этот внутриклеточный паразит обитает в фагоцитах — клетках иммунной системы человека. Паразитируя внутри этих клеток, он ослабляет их способность уничтожать микроорганизмы, что снижает защитные функции организма.
Основным резервуаром бактерий служат позвоночные животные из отряда грызунов: крысы, мыши, зайцы, а также домашние животные — овцы, свиньи и кролики. Человек заражается чаще всего через укусы комаров или клещей, а также контактным способом, реже — алиментарным.
| Причина | Симптомы | Диагностика и лечение |
|---|---|---|
| Бактерия Francisella tularensis (передаётся через укусы членистоногих, контакт с инфицированными животными, употребление в пищу заражённой воды или пищи, вдыхание аэрозолей) | Разнообразны, зависят от пути заражения: • Ульцеробуллёзная форма: язва на месте внедрения, лимфаденит (воспаление лимфатических узлов), лихорадка. • Глазная форма: конъюнктивит, лимфаденит. • Орофарингеальная форма: ангина, лимфаденит. • Лёгочная форма: кашель, боль в груди, лихорадка, одышка. • Тифоидная форма: высокая лихорадка, головная боль, слабость, увеличение селезёнки и печени. |
• Анализ крови: выявление антител к F. tularensis. • Бактериологическое исследование: выделение бактерии из образцов крови, лимфы, мокроты или других материалов. • ПЦР: обнаружение ДНК бактерии. Лечение: • Стрептомицин, гентамицин, доксициклин, ципрофлоксацин (антибиотики). • Симптоматическая терапия: жаропонижающие, обезболивающие средства. |
Структура и морфологические свойства Francisella tularensis
Francisella tularensis — небольшая кокковидная бактерия размером 0,3–0,5 мкм. Она неподвижна, не формирует жгутиков и спор, окружена тонкой капсулой, что придаёт ей устойчивость к внешним условиям.
Бактерии быстро погибают при высоких температурах, но стойки к низким. Например, при кипячении они уничтожаются за минуту, а при 0 градусах Цельсия могут выживать до 10 месяцев. В зерновых культурах, почве и на шкурах мертвых животных они сохраняются более полугода.
В лаборатории Francisella tularensis растёт медленно, требуя специальных сред, обогащённых витаминами и глюкозой. Это строгий аэроб, нуждающийся в кислороде для существования; в бескислородной среде он погибает.
Существует несколько подвидов этой бактерии. Выделяют два: подвид А и подвид В. Подвид А обладает высокой патогенностью и рассматривается как потенциальное биологическое оружие. В лабораторных испытаниях одна клетка подвида А может вызвать смерть кроликов, тогда как для подвида В требуется один миллиард клеток. Подвид В менее патогенен и вызывает более лёгкие формы туляремии; он встречается в Северной Америке, Азии и Европе.
По географическому распространению выделяют американский, среднеазиатский и европейско-азиатский подвид.
Туляремия — это инфекционное заболевание, вызываемое бактерией Francisella tularensis. Люди часто обсуждают её опасность, так как болезнь может передаваться через укусы насекомых, контакт с заражёнными животными или даже через воду. Симптомы варьируются от лихорадки и озноба до более серьёзных проявлений, таких как воспаление лимфатических узлов и пневмония. Диагностика включает серологические тесты и культивирование бактерий, что может быть затруднительно из-за разнообразия клинических проявлений. Лечение обычно основано на антибиотиках, таких как стрептомицин или доксициклин, и требует своевременного вмешательства, чтобы избежать осложнений. Важно помнить о профилактике, особенно для людей, работающих в сельском хозяйстве или охоте.

Основные факторы патогенности
Факторы патогенности — это структуры бактерий, способствующие их проникновению и распространению в организме, а также адаптации к окружающей среде. Например, капсула возбудителя туляремии защищает его от дезинфицирующих средств и способствует адгезии к клеткам хозяина.
Ключевые факторы патогенности возбудителя туляремии:
- капсула;
- белки внешней мембраны;
- липополисахарид;
- ферменты.
Капсула
Капсула — тонкая оболочка, состоящая на 70% из липидов и на 30% из белков. Липиды имеют сложную структуру и связаны с полисахаридами. Капсула может содержать кислоты или аминокислоты, что обеспечивает защиту бактерий от высыхания. Вещества в капсуле могут служить питательными веществами в неблагоприятных условиях. Капсула также активирует антимикробный ответ организма и стимулирует иммунную систему.
Белки внешней мембраны
Внешняя мембрана окружает бактериальную клетку и состоит из белков (15-20%), углеводов (15-30%) и липидов (40%). Белковый состав включает 25 фракций, которые влияют на активность макрофагов, захватывающих патогенные бактерии. Однако возбудитель туляремии нарушает эту функцию: он проникает в фагоциты и нарушает их работу, а некоторые белки связываются с антителами, что снижает активность макрофагов и системы комплимента.
Липополисахарид
Липополисахарид — компонент внешней мембраны, состоящий из полисахаридов и липидов. Он является основным фактором патогенности Francisella tularensis и ключевым антигеном. Липидная часть функционирует как эндотоксин, высвобождающийся при разрушении клетки. При попадании бактерий в кровь и их разрушении выделяется эндотоксин, вызывающий интоксикацию и возможный токсический шок.
Полисахаридная часть обладает антигенными свойствами и стимулирует гуморальный иммунитет. Липополисахарид участвует в переходе бактерий из активной формы в неактивную, что затрудняет диагностику туляремии с использованием бактериологических методов.
Ферменты
Возбудитель туляремии имеет разнообразные ферменты, способствующие прикреплению бактерий к клеткам и их проникновению внутрь макрофагов. Основной фермент — нейраминидаза, разрушающая рецепторы на поверхности клеток, что облегчает проникновение бактерий. Нейраминидаза также обладает антигенными свойствами.
Антигенная структура
Francisella tularensis обладает сложной антигенной структурой, включающей клеточные компоненты, вызывающие иммунный ответ. Основными стимуляторами являются капсула, липополисахарид, белки и ферменты. Ключевыми антигенами выступают элементы липополисахарида и клеточной стенки: поверхностный (Vi) антиген, связанный с клеточной стенкой, и соматический или ядерный (О) антиген.

Патогенез возбудителя туляремии
Возбудитель туляремии проникает в организм через кожу, слизистые оболочки или дыхательные пути. На месте внедрения образуется очаг — небольшое изъявление. Бактерии распространяются с лимфой по лимфатическим узлам, вызывая лимфаденит — увеличение лимфатических узлов. Сильно увеличенный лимфатический узел называется бубон. При гибели бактерий в кровь выбрасывается эндотоксин, что приводит к интоксикации. Затем бактерии попадают в кровь, вызывая бактериемию и воспалительные процессы в легких, печени и селезенке. Внутри органов образуются туляремийные гранулемы — бело-желтые округлые образования размером от 1 до 4 мм с участками омертвения в центре. Francisella tularensis вызывает аллергическую реакцию в иммунной системе.
Возбудитель туляремии обитает в организме определенных животных, являющихся источниками инфекции.
К источникам бактерий туляремии относятся:
- грызуны – полевка обыкновенная, водяная крыса, домашняя мышь, ондатра;
- зайцеобразные – зайцы, кролики, пищухи;
- домашние животные – крупный и мелкий рогатый скот (коровы и овцы), свиньи.
Человек может заразиться при контакте с ними или через зараженные продукты и воду. Чаще всего заражение происходит через переносчиков инфекции — кровососущих членистоногих: клещей, слепней, комаров и блох. Жизненный цикл бактерий сохраняется в цепочке «клещ – животное». Восприимчивость человека к инфекции составляет 100%, но больной туляремией не опасен для окружающих.
Пути инфицирования туляремией
| Пути передачи | Как происходит заражение |
| Трансмиссивный | Заражение через укус блох, слепней и других членистоногих, которые переносят бактерии от источника (грызунов, зайцеобразных) к человеку. |
| Контактный | При непосредственном контакте с источником туляремии (животным или грызуном) или с предметами, загрязненными их выделениями. |
| Аэрогенный | При вдыхании воздуха и частичек пыли, содержащих туляремийные бактерии. |
| Водный | При употреблении зараженной воды. |
| Алиментарный | При употреблении продуктов от больных животных, например, мяса инфицированного кролика. |
Наиболее распространенный путь заражения — через укусы насекомых. Контактный путь чаще встречается в сельской местности, где наблюдаются вспышки заболевания. В группу риска входят фермеры, рыбаки и охотники.
Наибольшему риску контактного заражения подвержены охотники и работники мясокомбинатов. Заражение происходит при разделке туш животных или обработке их шкур. Чаще всего развиваются бубонная и язвенно-бубонная формы, первичный аффект локализуется на кистях рук. Если человек дотрагивается до глаз грязными руками, возможно проникновение возбудителя через слизистую и развитие глазобубонной формы.
Заражение происходит при вдыхании инфицированного воздуха. Бактерии, попадая в дыхательную систему, вызывают легочную форму туляремии. Этот механизм чаще затрагивает работников ферм. Бактерии попадают в воздух при разделке шкур животных или обмолоте хлеба. В группу риска входят работники мельниц и фермеры.
Заражение происходит при употреблении воды или пищи, инфицированных бактериями. С мочой и экскрементами зараженных грызунов бактерии попадают в водоемы, почву и скирды зерновых. При купании в таких водоемах или употреблении воды из них бактерии проникают в желудочно-кишечный тракт. Для этого пути заражения характерно развитие абдоминальной формы туляремии.
Вспышки туляремии имеют сезонность и природную очаговость. Язвенно-бубонная и бубонная формы чаще всего наблюдаются весной, легочная и ангинозная — осенью. Трансмиссивный путь инфицирования наиболее распространен в июле и августе.
Природные очаги туляремии:
- пойменно-болотный;
- луго-полевой;
- лесной;
- степной (мышиный);
- тундровый;
- предгорно-ручьевой.
Эти очаги отличаются высокой устойчивостью. В них возбудитель сохраняется благодаря источникам (грызунам, зайцеобразным) и переносчикам (кровососущим членистоногим).
Виды вспышек туляремии:
- сельскохозяйственная – возникает при работе с сеном, соломой, зерновыми;
- промышленная – возникает весной в период половодья и связана с отловом ондатры или водяной крысы;
- водная – начинается в начале лета, обусловлена полевыми работами и использованием открытых водоемов;
- бытовая – возникает при работе дома или на даче, например, при раздаче корма животным или обработке продуктов.
Симптоматика туляремии разнообразна и включает общие признаки интоксикации и специфические симптомы.
Общие симптомы туляремии:
- высокая температура;
- озноб;
- резкая головная боль;
- боль в мышцах;
- инъекция сосудов склеры;
- сыпь.
Заболевание начинается с резкого повышения температуры до 39 градусов Цельсия, сопровождающегося ознобом, и может длиться от двух до трех недель. У пациента возникают сильные головные боли, тошнота, иногда рвота. Конъюнктива глаз становится ярко-красной, на теле появляется сыпь. Эти симптомы связаны с интоксикацией и действием эндотоксина. Основным специфическим симптомом является регионарный лимфаденит (увеличение лимфатических узлов).
Дальнейшая клиническая картина зависит от входных ворот и локализации патологического процесса. Условно выделяют локальные формы туляремии с поражением кожи, слизистых и лимфатических узлов, а также формы с преобладанием поражения внутренних органов.
Локальные формы туляремии:
- бубонная;
- язвенно-бубонная;
- глазобубонная;
- ангинозно-бубонная.
Бубонная форма
Основной симптом — бубон — увеличенный лимфатический узел, развивающийся из-за размножения бактерий в лимфатических узлах. Бубоны могут быть одиночными или множественными, чаще всего подмышечные, паховые или бедренные. Они появляются на 3-5 день болезни, начальный размер составляет 2-3 сантиметра. Бубоны болезненны и могут увеличиваться до 8-10 сантиметров. Кожа над ними долго сохраняет окраску.
Эволюция бубонов может быть разнообразной. У половины больных они регрессируют в течение 2-4 месяцев, у другой половины наблюдается нагноение. В этом случае содержимое бубонов размягчается, кожа становится отечной, а бубоны болезненными и горячими. Гнойное содержимое имеет густую консистенцию, белого цвета и не обладает ярко выраженным запахом.
Язвенно-бубонная форма
Для этой формы также характерны бубоны и общие симптомы интоксикации. Отличием является наличие первичного аффекта — небольшой язвы на месте внедрения бактерий, окруженной ободком («кокарда»).
Сначала формируется пятнышко, затем папула, пузырек. На 5-7 день пузырек нагнаивается, формируется пустула. Когда пустула прорывается, на ее месте образуется малоболезненная язва с приподнятыми краями и темной корочкой.
Глазобубонная форма
Эта форма встречается редко, в 1-2 процентах случаев. Она характеризуется поражением глаз, когда возбудитель попадает на слизистую. Развивается фолликулярный конъюнктивит и язвенные поражения слизистой. Конъюнктива становится ярко-красной, образуются фолликулы, затрудняющие движение глаз.
Ангинозно-бубонная форма
Эта форма встречается менее чем в одном проценте случаев. Она характеризуется поражением небных миндалин и развитием тонзиллита. Заболевание начинается с резких болей в горле, трудностей при глотании. На миндалинах образуются фибриновые пленки и некротические изъязвления. Увеличиваются шейные и околоушные лимфатические узлы.
Эта форма развивается при аэрогенном или алиментарном заражении. Бактерии оседают в лимфатических узлах и внутренних органах, вызывая воспаление. В органах формируются туляремийные гранулемы, аналогичные туберкулезным.
Формы туляремии с поражением внутренних органов:
- легочная;
- абдоминальная.
Легочная форма
При этой форме поражаются органы дыхательной системы. Легочная форма может протекать с преобладанием поражения легочной ткани и развитием пневмонии или с поражением бронхов и развитием бронхита.
Заболевание начинается с болей в грудной клетке. В первые дни появляется сухой кашель, который становится влажным. Мокрота скудная, слизистого или слизисто-гнойного характера. В тяжелых случаях может содержать кровь.
Бронхитический вариант отличается умеренной интоксикацией и более легким течением. Заболевание продолжается от двух до трех недель.
Пневмонический вариант характеризуется тяжелым течением и рецидивами. Поражаются медиастинальные лимфатические узлы. Длительность этой формы составляет от двух месяцев и более.
Абдоминальная форма
При этой форме поражаются мезентериальные лимфатические узлы. Основные симптомы — боль в животе, рвота и расстройства стула. Бактерии попадают в печень и селезенку, вызывая их увеличение и болезненность (гепатоспленомегалия). Грозным осложнением является кишечное кровотечение.
Эта форма является самой тяжелой и развивается у людей с ослабленным иммунитетом. В крови наблюдается большое количество бактерий и их токсинов, что называется сепсисом.
Симптомы генерализованной формы:
- температура 39-40 градусов Цельсия;
- озноб;
- сниженное артериальное давление;
- аритмия;
- одышка;
- спутанное сознание;
- сыпь.
При этой форме отсутствуют местные изменения. Заболевание характеризуется выраженной интоксикацией, иногда токсическим шоком. Бактерии могут поражать сердце, легкие и мозг, что приводит к полиорганной недостаточности.
Давление резко падает, наблюдаются перебои в работе сердца, спутанность сознания, может развиваться бред. Быстро нарастает дыхательная недостаточность. При этой форме могут развиваться менингиты и энцефалиты. Бактерии часто поражают сердечную мышцу, что приводит к миокардиодистрофии.
При подозрении на туляремию необходимо обратиться к инфекционисту или семейному врачу. Врач проводит опрос пациента о времени появления симптомов, их характере и интенсивности, а также эпидемиологический анамнез. Далее проводится общий осмотр и физикальное обследование. На основе полученных данных медик может назначить дополнительные исследования для подтверждения или опровержения диагноза.
Жалобы пациентов с туляремией
При выслушивании пациента врач фиксирует жалобы и уточняет их характер. Пациенты жалуются на высокую температуру, которая длится долго и не снижается жаропонижающими средствами. Инфицированный человек испытывает сильные головные боли и болезненные ощущения в мышцах. Также характерны слабость, общее недомогание и снижение работоспособности. Часто наблюдаются тошнота, отсутствие аппетита и другие симптомы пищевого отравления.
Другие жалобы:
- повышенное потоотделение;
- озноб;
- проблемы со сном;
- снижение артериального давления;
- кожная сыпь;
- увеличение лимфатических узлов.
В зависимости от типа заболевания картина может дополняться другими жалобами. При укусе инфицированных животных или насекомых пациентов беспокоит болезненность лимфатических узлов в области укуса. В некоторых случаях больные жалуются на боль в глазах. На месте проникновения инфекции могут образовываться язвы, которые вскоре прорываются, выделяя густой гной. При употреблении зараженного мяса у человека развивается водянистый понос и сильные боли в области ребер. При виде или упоминании еды может возникать рвота. При воздушно-капельном заражении больной жалуется на сильную боль в груди, кашель и одышку.
Опрос пациента
Цель опроса — выяснение начала заболевания. Врач спрашивает о времени появления симптомов и их особенностях, обращает внимание на динамику проявлений. Также старается определить источник инфекции и способ заражения. Ответы помогают установить диагноз и предотвратить заражение других людей.
Вопросы для эпидемиологического анамнеза:
- наличие сходных симптомов у соседей, коллег, членов семьи;
- участие в охоте, рыбалке, туристических походах;
- поездки за границу;
- укусы животных или насекомых;
- профессиональная сфера деятельности;
- участие в забое скота или разделке животных;
- соблюдение санитарных норм условий работы или проживания;
- употребление некипяченой воды, сырого молока, слабопрожаренного мяса, немытых фруктов и овощей.
Физикальный осмотр
Во время осмотра врач исследует кожные покровы, глазные склеры и ротовую полость. Проводится пальпация живота и общий осмотр. Анализируя внешние признаки туляремии, врач делает вывод о форме и других нюансах заболевания.
Внешние симптомы туляремии:
- увеличенные лимфатические узлы;
- покраснение глаз;
- воспаленная слизистая горла;
- увеличенная печень и селезенка (при редкой тифоидной форме);
- хрипы и ослабленные дыхательные шумы (при туляремической пневмонии);
- гиперемия кожи в области лимфатических узлов;
- сыпь на коже в виде мелких кровоизлияний;
- отекшее и припухшее лицо;
- синюшно-багровый оттенок лица;
- кровоизлияния в форме точек на слизистой рта.
Основным внешним проявлением туляремии являются воспалительные папулы. Этот признак характерен для локальных форм заболевания. Местами формирования папул могут быть руки, подмышечные впадины, глаза и небо. Вскоре папулы заполняются гноем и прорываются, образуя язвенный кратер.
Лабораторная диагностика туляремии включает несколько методов. Из-за разнообразной клинической картины эти методы играют решающую роль в диагностике. Материалом для исследования могут служить гнойное содержимое из бубонов, мокрота или кровь.
Методы лабораторного исследования:
- аллергический метод;
- серологические методы;
- бактериологические методы.
Аллергический метод
Этот метод включает кожные тесты, проводимые в первую неделю болезни. Они основаны на проявлении местной аллергической реакции у людей с туляремией, обусловленной наличием аллергического компонента.
Тест заключается во внутрикожном введении тулярина и в развитии соответствующей реакции. Тулярин — биологический препарат из убитых туляремийных бактерий. Его наносят на кожу предплечья скарификационным методом. Через 24-48 часов появляется местная аллергическая реакция в виде покрасневшего уплотнения. Если инфильтрат более 5 мм, реакция считается положительной.
Преимущества метода — высокая специфичность, простота и быстрота проведения, положительный результат уже с 3-5 дня заболевания.
Серологические методы
Эти методы основаны на реакции антиген-антитело. Антитела — белки, синтезируемые иммунной системой в ответ на чуждые бактерии. Антигены — структуры бактерий, способные стимулировать иммунный ответ. В диагностике туляремии чаще всего используется реакция агглютинации (РА).
Для постановки реакции берут 3 мл крови, из которой получают сыворотку. В качестве антигена используется туляремийный диагностикум. Реакцию ставят как на стекле (ориентировочная реакция), так и в пробирке (развернутая реакция).
Сначала на стекле смешивают каплю сыворотки и туляремийного диагностикума. Если образуется осадок в виде хлопьев, реакция положительная. Далее проводится более подробная развернутая реакция в пробирке.
Еще одной чувствительной реакцией является реакция непрямой гемагглютинации (РПГА). Она основывается на том же принципе, но антигены сорбируются на поверхности эритроцитов, что приводит к склеиванию и выпадению в осадок.
Бактериологические и биологические методы
Эти методы основаны на выделении чистых культур бактерий на специальные среды. Сначала применяют биологическую пробу. Для этого материал от больного заражают лабораторных свинок. После заражения берут кровь и засевают на специальные среды. Колонии туляремийных бактерий растут в виде небольших капель.
Детоксикация организма — важный этап в лечении туляремии. Она направлена на выведение токсинов и бактерий из организма. Для этого используются коллоидные растворы с витаминами группы В и сорбенты. Также применяется форсированный диурез.
Препараты для детоксикации
| Название препарата | Механизм действия | Как принимать |
| Реамберин | Уменьшает свободные радикалы, восстанавливает энергетические обмены, устраняет кислородное голодание клеток. | Суточная доза 500-800 мл, вводится внутривенно капельно. |
| Поливедон | Связывает токсины и выводит их, усиливает почечный кровоток. | Разовая доза 200-400 мл, вводится внутривенно капельно. |
| Венофундин | Увеличивает объем циркулирующей крови. | Доза 250-500 мл, вводится медленно. |
| Витамин С | Обладает антигипоксическим действием. | Вводится внутривенно, затем можно перейти на внутримышечное введение. |
| Пиридоксин (витамин В6) | Активирует обменные процессы, усиливает энергетические процессы в нервной ткани. | Применяется внутривенно или внутримышечно. |
| 20-процентный раствор глюкозы + фуросемид | Глюкоза повышает объем жидкости, фуросемид выводит ее через почки. | 800 мл глюкозы вводят внутривенно, через час вводят фуросемид. |
Антибиотикотерапия играет ключевую роль в лечении туляремии. Используются антибиотики из группы аминогликозидов (стрептомицин, гентамицин) и тетрациклинового ряда (тетрациклин, доксициклин).
Антибиотики для лечения туляремии
| Название препарата | Механизм действия | Как принимать |
| Стрептомицин | Проникает внутрь бактерий и нарушает синтез белков. | Вводится внутримышечно по 500 мг дважды в день. |
| Гентамицин | Вводится внутримышечно по 80 мг дважды в день. | |
| Доксициклин | Ингибирует синтез белков, что приводит к гибели клеток. | Внутрь по 100 мг дважды в день. |
| Тетрациклин | Внутрь по 500 мг 4 раза в сутки. |
Вакцинация от туляремии предназначена для предотвращения заражения. Вакцину назначают всем возрастным группам с 7 лет.
Когда назначается?
Вакцинация проводится в зависимости от эпидемиологических особенностей. По особым показаниям осуществляется плановая вакцинация всего населения определенного района, за исключением детей до 7 лет и лиц с противопоказаниями.
Условия для вакцинации всего населения:
- зарегистрированные случаи заболевания туляремией в данном районе в прошлом;
- случаи заболевания в смежных районах;
- доказанное присутствие возбудителя в организмах животных.
При отсутствии эпидемиологических показаний плановая вакцинация проводится только особым контингентам.
Лица для плановой вакцинации в неэпидемиологических зонах:
- сельскохозяйственные работники;
- работники, имеющие дело со скотом;
- дератизаторы;
- дезинсекторы;
- работники санитарно-противоэпидемической службы;
- лица, временно посещающие эпидемические районы;
- работники меховых фабрик;
- персонал лабораторий, работающий с культурами бактерий туляремии.
При увеличении численности грызунов и выявлении туляремии среди животных назначается экстренная вакцинация населения, в первую очередь работников сельского хозяйства. При регистрации случаев заражения среди людей проводится вакцинация всего населения в кратчайшие сроки.
Что содержит вакцина?
Туляремийная вакцина содержит ослабленные бактерии, выращенные на специальных средах. Для вакцинации лиофилизат растворяется дистиллированной водой и вводится подкожно.
Введение вакцины от туляремии
| Накожный способ | Подкожный способ | |
| Доза препарата | 2 капли раствора. | 0,1 миллилитра раствора. |
| Место введения | Средняя треть плеча. | Средняя треть плеча. |
| Техника выполнения | Обработка кожи, нанесение вакцины, скарификация. | Обработка кожи, введение раствора с помощью инъектора. |
Эффективность вакцинации
Эффективность вакцинации высока. Введение ослабленных бактерий приводит к образованию специфических антител. Полное формирование иммунитета происходит через 20-30 дней. Стойкий противотуляремийный иммунитет сохраняется до пяти лет. По истечении этого срока возможна ревакцинация.
Реакция и противопоказания для вакцинации
Местная реакция на прививку должна развиваться у всех пациентов. При накожном методе на месте насечек появляются покраснения и отек. У некоторых может наблюдаться увеличение и болезненность лимфатических узлов.
При внутрикожной вакцинации могут возникать припухлость и покраснение. В течение 2-3 суток могут развиваться общее недомогание, головная боль и повышенная температура. Перед вакцинацией проводится опрос для выявления противопоказаний.
Противопоказания для вакцинации:
- обострения хронических заболеваний;
- острые болезни;
- иммунодефицит;
- злокачественные болезни крови;
- новообразования;
- склонность к аллергическим заболеваниям;
- беременность и период грудного вскармливания.
Вскрытие нагноившихся бубонов производится редко, так как они могут прорываться сами. В этом случае рекомендуется обрабатывать открытую рану антисептиком и накладывать повязку с тетрациклиновой или стрептомициновой мазью.
Если бубон не вскрывается самопроизвольно, рекомендуется хирургическое вмешательство. Вскрытие проводится под местной анестезией.
Техника проведения
Манипуляция должна проводиться в стерильных условиях. Кожу над бубоном обрабатывают раствором йода, затем делают широкий разрез. После разреза из раны вытекает гной, который необходимо эвакуировать. Образовавшуюся полость обрабатывают антисептиком и накладывают повязку с мазью.
Профилактика туляремии заключается в ограничении контактов с потенциальными носителями. Необходимо соблюдать предосторожность и правила личной гигиены в зонах с повышенным риском.
Мероприятия для предотвращения заболевания:
- соблюдение мер предосторожности на природе;
- выполнение правил безопасности при работе в саду;
- вакцинация.
Следует придерживаться правил, помогающих предотвратить заболевание туляремией, людям из группы риска.
В природных условиях существуют местности с повышенным риском инфицирования. Заразиться можно во время охоты, рыбалки, туристических походов.
Источники инфекции на природе:
- клещи;
- комары;
- слепни;
- блохи;
- водяные крысы;
- ондатры;
- зайцы.
Интенсивность циркуляции возбудителей зависит от местности и времени года. Наибольшая вероятность инфицирования наблюдается весной, летом и начале осени.
Зоны, где преобладают животные и насекомые, распространяющие инфекцию:
- болота;
- местности вблизи ручьев;
- поймы рек;
- озера;
- поля;
- луга;
- степи;
- леса.
Чтобы предотвратить контакт с переносчиками, необходимо носить специальную одежду и обрабатывать кожу защитными средствами. Следует правильно выбирать места для стоянок и соблюдать правила личной гигиены.
Средства защиты от насекомых различаются по характеристикам. Выбирая продукцию, необходимо учитывать условия использования и продолжительность действия.
Средства против насекомых:
- метод воздействия;
- форма выпуска препарата;
- тип применения.
Способы воздействия защитных средств
Продукция делится на репелленты, акарицидные средства и комбинированные препараты.
Репелленты содержат токсическое вещество, отпугивающее насекомых. Эти средства наносятся на одежду и открытые участки тела. Существуют средства для детей и те, которые нельзя наносить на кожу. Наиболее эффективны репелленты против комаров.
Препараты-репелленты:
- рефтамид максимум;
- бибан;
- дэта-ВОККО.
Акарицидные средства содержат вещество, оказывающее нервнопаралитическое действие на насекомых. Эти препараты наносятся только на одежду.
К акарицидным препаратам относятся:
- рефтамид таежный;
- пикник антиклещ.
Комбинированные препараты содержат два активных вещества и могут использоваться для защиты от клещей и летающих насекомых.
Средства комбинированного действия:
- медилис-комфорт;
- москитол-спрей.
Форма выпуска отпугивающих препаратов
Препараты выпускаются в форме аэрозолей, лосьонов, кремов и карандашей. Также доступны средства в виде браслетов. Аэрозольная форма наиболее удобна, но обладает меньшей продолжительностью действия.
Тип использования
Средства могут быть предназначены для личного или коллективного применения. К препаратам группового использования относятся свечи, фумигаторы и ловушки.
Правила использования защитных средств
Для повышения эффективности и предотвращения побочных эффектов необходимо соблюдать ряд правил.
Правила применения средств защиты:
- проверять срок годности и лицензию;
- обновлять препарат по истечении срока действия;
- активное потоотделение сокращает период действия средств на коже;
- время действия препаратов, наносимых на одежду, уменьшается при дожде.
При посещении зон с повышенным риском заражения туляремией необходимо надевать одежду, максимально закрывающую кожу. Рекомендуется носить брюки и кофты с длинным рукавом, головные уборы. Оптимальным вариантом является специальный противоклещевой костюм.
Правила поведения на природе
Во время туристических походов необходимо тщательно выбирать место для стоянки. Не следует устанавливать палатки рядом с норами животных. Периодически осматривайте тело и одежду на предмет наличия клещей.
Профилактические меры во время отдыха на природе:
- всю воду следует кипятить;
- после контакта с животным необходимо мыть руки;
- нельзя употреблять сырое или полусырое мясо;
- вся пища должна быть тщательно прожарена или доведена до кипения;
- нельзя собирать грибы или ягоды с следами помета.
Защиту от клещей и насекомых следует обеспечить домашним животным. Для отпугивания используются различные спреи и ошейники. Не следует оставлять животных без присмотра.
Во время работы в саду необходимо использовать респираторы или ватно-марлевые повязки. Также носите перчатки и высокую обувь. В помещениях, долго не использовавшихся, проведите влажную уборку с дезинфицирующими средствами. На садовых участках поддерживайте чистоту.
Людям, занимающимся разведением животных, необходимо соблюдать меры предосторожности. Бактерии могут находиться в фекалиях, шкурах и продуктах жизнедеятельности.
Сельскохозяйственные животные, восприимчивые к туляремии:
- кролики;
- нутрии;
- поросята;
- ягнята;
- цыплята.
Заразиться туляремией можно во время уборки помещений, кормления животных и разделки туш. Все работы следует проводить в перчатках и защитных масках. После контакта с животными необходимо мыть руки.
Предприятия, занимающиеся разведением животных и переработкой сельскохозяйственных продуктов, представляют собой очаги повышенного риска.
Специальности с высокой вероятностью заражения:
- пастухи;
- рыболовы и охотники;
- сотрудники мясных комбинатов;
- специалисты по заготовке и переработке сельскохозяйственной продукции.
Руководство предприятий должно обеспечивать мероприятия по уничтожению грызунов и защищать территорию от проникновения мышей и крыс.
Способы инфицирования туляремией
Возбудитель туляремии обитает в организме определенных животных, которые являются источниками инфекции.
Основные источники бактерий туляремии:
- Грызуны – полевка обыкновенная, водяная крыса, домашняя мышь, ондатра;
- Зайцеобразные – зайцы, кролики, пищухи;
- Домашние животные – крупный и мелкий рогатый скот (коровы, овцы), свиньи.
Эти животные служат естественной средой для бактерий туляремии. Человек может заразиться при непосредственном контакте с ними или через инфицированные продукты и воду. Однако чаще всего заражение происходит косвенно через переносчиков инфекции: кровососущих членистоногих, таких как клещи, слепни, комары и блохи. Туляремийные бактерии передаются от животных к человеку через укусы этих насекомых. Жизненный цикл бактерий поддерживается в цепочке «клещ – животное». Восприимчивость человека к инфекции составляет 100 процентов, но больной туляремией не представляет угрозы для окружающих.
Пути инфицирования туляремией
| Пути передачи | Как происходит заражение |
| Трансмиссивный | Заражение через укус блох, слепней и других членистоногих, которые переносят бактерии от источника (грызунов, зайцеобразных) к человеку. |
| Контактный | При непосредственном контакте с источником туляремии (животным или грызуном) или с предметами, загрязненными их выделениями. |
| Аэрогенный | При вдыхании воздуха и частиц пыли, содержащих туляремийные бактерии. |
| Водный | При употреблении воды, зараженной бактериями туляремии. |
| Алиментарный | При потреблении продуктов от инфицированных животных, например, мяса зараженного кролика. |
Трансмиссивный путь
Заражение туляремией происходит через укусы насекомых. Клещи и комары переносят возбудителя, который проникает в кровеносную и лимфатическую системы человека. Этот способ передачи инфекции распространен среди взрослых и детей.
Контактный путь заражения
Контактный путь передачи инфекции чаще всего встречается в сельских районах, где происходят основные вспышки заболевания. В группу риска входят фермеры, рыбаки и охотники.
Наибольшую вероятность заражения туляремией контактным способом имеют охотники и работники мясокомбинатов. Инфекция может произойти при разделке туш животных или обработке их шкур. В таких случаях развиваются контактные формы туляремии, такие как бубонная и язвенно-бубонная. Первичное поражение возникает на руках, в местах прямого контакта с инфицированным животным. При касании глаз немытыми руками существует риск проникновения возбудителя через слизистую оболочку, что может привести к глазобубонной форме заболевания.
Аэрогенный путь
Заражение происходит при вдыхании воздуха с инфекционными частицами пыли. Бактерии проникают в дыхательные пути и могут вызвать легочную форму туляремии. Наибольшему риску подвержены сотрудники фермерских хозяйств, особенно во время разделки шкур животных. Инфекция также может передаваться при обмолоте зерна, когда бактерии попадают в легкие или конъюнктиву из нижних слоев стогов пшеницы. В группу риска входят работники мельниц, фермеры и специалисты по обработке зерновых и кормовых культур.
Водный и алиментарный пути заражения
Инфекция возникает при употреблении пищи или воды, содержащих бактерии туляремии. Эти бактерии с мочой и фекалиями зараженных грызунов попадают в водоемы, почву и скирды зерна. При купании в таких водоемах или употреблении их воды бактерии проникают в желудочно-кишечный тракт и инфильтруют лимфатические узлы, что обычно приводит к абдоминальной форме туляремии. Также бактерии могут попасть в организм при употреблении сырого мяса или контакте с ним.
Сезонность и очаговость туляремии
Вспышки туляремии имеют сезонность и природную очаговость. Язвенно-бубонная и бубонная формы заболевания чаще проявляются весной, что связано с началом охоты на водяных крыс. Легочная и ангинозная формы более распространены осенью из-за высокого уровня инфицирования диких грызунов. Трансмиссивный путь передачи инфекции наблюдается в июле и августе, а максимальная заболеваемость фиксируется во время сенокоса и уборки урожая.
Природные очаги туляремии:
- пойменно-болотный;
- луго-полевой;
- лесной;
- степной (мышиный);
- тундровый;
- предгорно-ручьевой.
Эти очаги устойчивы, возбудитель туляремии сохраняется и распространяется через источники инфекции (грызуны и зайцеобразные) и переносчиков (кровососущие членистоногие). Каждый очаг имеет свои виды животных и типы кровососущих. Например, для водных вспышек основными источниками являются водяные крысы, для степных – мыши, а для болотных – полевки.
Кроме природной очаговости, выделяют несколько типов вспышек туляремии, каждая из которых имеет свои особенности заболеваемости и течение болезни.
Типы вспышек туляремии:
- сельскохозяйственная – возникает при работе с сеном, соломой и зерновыми культурами;
- промышленная – проявляется весной во время половодья, связана с отловом ондатры или водяной крысы;
- водная – наблюдается в начале лета, связана с полевыми работами и использованием открытых водоемов;
- бытовая – возникает в домашних условиях или на даче, заражение происходит при кормлении животных, сушке и обработке продуктов, а также при уборке помещений.
Симптомы туляремии
Симптоматика туляремии разнообразна и включает общие признаки интоксикации и специфические проявления. Общие симптомы возникают в начале заболевания, независимо от его формы.
К основным общим симптомам туляремии относятся:
- высокая температура тела;
- озноб;
- сильная головная боль;
- мышечные боли;
- покраснение сосудов склеры;
- сыпь.
Заболевание начинается с резкого повышения температуры до 39 градусов Цельсия, сопровождающегося ознобом, который может длиться от двух до трех недель. У пациента возникают сильные головные боли, тошнота и иногда рвота. Конъюнктива глаз становится ярко-красной, на коже появляется сыпь. Эти проявления связаны с интоксикацией, вызванной эндотоксином, который высвобождается из погибших бактерий и вызывает повышение температуры и некротические изменения в коже. В этот период может возникнуть аллергическая реакция, приводящая к полиморфной сыпи. Основным специфическим признаком на этом этапе является регионарный лимфаденит — увеличение лимфатических узлов в определенной области.
Эти симптомы характерны для многих микробных инфекций, включая зоонозы.
Дальнейшая клиническая картина заболевания зависит от входных ворот инфекции и локализации патологического процесса. Выделяют локализованные формы туляремии, затрагивающие кожу, слизистые оболочки и лимфатические узлы, а также формы, при которых поражаются внутренние органы.
Локальные формы туляремии
Для туляремии характерно изолированное поражение кожи и сочетание с поражением слизистых оболочек.
Локальные формы туляремии:
- бубонная;
- язвенно-бубонная;
- глазобубонная;
- ангинозно-бубонная.
Эти формы чаще возникают при проникновении возбудителя через кожу.
Бубонная форма
Основной признак — бубон, увеличенный лимфатический узел, возникающий из-за размножения бактерий в лимфатических узлах. Бубоны могут быть одиночными или множественными, чаще всего подмышечные, паховые или бедренные. Они появляются на 3-5 день болезни, начальный размер — 2-3 сантиметра. Увеличенные лимфатические узлы болезненны. По мере прогрессирования заболевания бубоны могут достигать 8-10 сантиметров и становятся заметными под кожей. Несмотря на размеры, они с подкожной жировой клетчаткой связаны не очень плотно, что придаёт им подвижность. Кожа над ними долго сохраняет окраску.
Эволюция бубонов различна. У половины пациентов они уменьшаются в течение 2-4 месяцев. У другой половины возможны нагноения: содержимое размягчается, кожа становится отечной, бубоны болезненными, плотными и горячими. Боль уменьшается при выходе гноя, который имеет густую консистенцию, белый цвет и не выраженный запах. Он состоит из омертвевших клеток, клеток воспаления и бактерий туляремии.
Язвенно-бубонная форма
Эта форма также сопровождается образованием бубонов и симптомами интоксикации. Её отличает первичный аффект в месте внедрения бактерий — небольшая язва с ободком («кокарда»).
Сначала на месте внедрения бактерий появляется пятно, затем папула, потом пузырек. На 5-7 день пузырек нагнаивается, образуя пустулу — глубокое образование с гнойным содержимым. При прорыве пустулы образуется малоболезненная язва с приподнятыми краями, что придаёт ей кратерообразный вид. По краям образуется тёмная корочка с шелушащимися краями — «кокарда».
Глазобубонная форма
Эта форма встречается редко, в 1-2% случаев, и характеризуется поражением глаз. Развивается при попадании возбудителя на слизистую оболочку глаз. Для неё характерны фолликулярный конъюнктивит и язвенные поражения слизистой. Конъюнктива ярко-красная, образует множество фолликулов, что затрудняет движение глаз. Из глаз выделяется густой желтоватый гной.
Ангинозно-бубонная форма
Эта форма встречается менее чем в 1% случаев и характеризуется поражением небных миндалин, то есть тонзиллитом. Заболевание начинается с резкой боли в горле из-за увеличения миндалин. Пациент испытывает трудности при глотании и отказывается от еды. На миндалинах образуются фибриновые пленки и множественные некротические изъязвления. Позже формируются глубокие язвы, замещающиеся рубцовой тканью. Это происходит на фоне интоксикации и высокой температуры. Увеличиваются шейные и околоушные лимфатические узлы. Динамика бубонов при ангинозно-бубонной форме аналогична другим формам.
Туляремия с поражением внутренних органов
Эта форма туляремии возникает при заражении через воздух или пищу. Бактерии проникают в организм, оседая в лимфатических узлах и внутренних органах, вызывая специфическое воспаление. В результате формируются гранулемы, напоминающие туберкулезные, с центром из мертвой ткани и бактерий туляремии, что нарушает функции пораженных органов. Со временем в гранулемах накапливаются соли кальция, что приводит к их кальцификации. В зависимости от пораженного органа выделяют несколько форм туляремии.
Формы туляремии с поражением внутренних органов:
- легочная;
- абдоминальная.
Легочная форма
При легочной форме затрагиваются легкие, трахея и бронхи. Она может проявляться как пневмония (пневмонический вариант) или бронхит (бронхитический вариант).
Заболевание начинается с резких болей в грудной клетке. В первые дни появляется сухой кашель, который быстро становится влажным. Мокрота обычно скудная и слизистая или слизисто-гнойная. В тяжелых случаях может содержать кровь (геморрагическая).
Бронхитический вариант характеризуется умеренной интоксикацией и более легким течением. Параллельно поражаются бронхиальные и парабронхиальные лимфатические узлы. Заболевание может длиться от двух до трех недель.
Пневмонический вариант имеет более тяжелое и затяжное течение, с периодическими обострениями и осложнениями, такими как абсцессы и плевриты. Поражаются медиастинальные лимфатические узлы. Длительность этой формы может составлять от двух месяцев и более.
Абдоминальная форма
При абдоминальной форме поражаются мезентериальные лимфатические узлы. Основные симптомы включают боли в животе, рвоту и расстройства стула. Бактерии могут попадать в печень и селезенку, вызывая их увеличение и болезненность, что называется гепатоспленомегалией. Одним из серьезных осложнений является кишечное кровотечение.
Генерализованная форма
Данная форма заболевания считается наиболее тяжелой и развивается у людей с ослабленным иммунитетом. В крови наблюдается большое количество бактерий туляремии и их токсинов. Это состояние называется сепсисом, поэтому генерализованная форма известна как септическая.
Симптомы генерализованной формы включают:
- температура 39–40 градусов Цельсия;
- озноб;
- пониженное артериальное давление;
- аритмия;
- одышка;
- спутанность сознания;
- сыпь.
При этой форме отсутствуют локальные проявления. Заболевание сопровождается выраженной интоксикацией, иногда развивается токсический шок. Характерно одновременное поражение нескольких органов и систем, что приводит к полиорганной недостаточности. Бактерии туляремии могут поражать сердце, легкие и мозг, преодолевая гематоэнцефалический барьер. Это вызывает сердечно-сосудистую, дыхательную и почечную недостаточности.
Артериальное давление резко снижается (менее 90 мм рт. ст.), возникают перебои в работе сердца. Сознание пациентов становится спутанным, может развиваться бред. Дыхательная недостаточность быстро прогрессирует. При генерализованной форме туляремии могут возникать менингиты и энцефалиты. Бактерии туляремии часто поражают сердечную мышцу, что приводит к миокардиодистрофии, проявляющейся одышкой, аритмией и ослаблением сердечной деятельности.
При данной форме заболевания сыпь появляется чаще, чем при других формах, из-за воздействия эндотоксина на капилляры. Кровь проникает в кожные покровы через поврежденные стенки капилляров. На руках и ногах возникает симметричная розеолезная сыпь, проявляющаяся в виде перчаток на руках, гетр на ногах, воротника на шее и груди или маски на лице. Изначально сыпь светло-красная, затем темнеет, приобретая медный оттенок, и исчезает через 10–14 дней.
Диагностика туляремии
Обследование у врача
При подозрении на туляремию необходимо обратиться к инфекционисту или семейному врачу. Специалист проведет опрос о времени появления и характеристиках симптомов, а также соберет информацию о возможных контактах с инфицированными людьми или животными и посещении опасных зон. Затем врач проведет осмотр и физикальное обследование. На основе собранных данных будут назначены дополнительные исследования для подтверждения или опровержения диагноза.
Жалобы, характерные для пациентов с туляремией
Врач фиксирует жалобы и уточняет их детали. Пациенты с туляремией часто сообщают о высокой температуре, которая длится долго и не снижается жаропонижающими средствами. Инфицированные испытывают сильные головные и мышечные боли, слабость, общее недомогание и снижение работоспособности. Часто наблюдаются тошнота, отсутствие аппетита и другие симптомы, схожие с пищевым отравлением.
К другим жалобам, типичным для этой инфекции, относятся:
- повышенное потоотделение;
- озноб;
- нарушения сна;
- пониженное артериальное давление;
- кожные высыпания;
- увеличение лимфатических узлов.
В зависимости от формы заболевания могут возникать и другие специфические жалобы. Например, при укусе инфицированных животных или насекомых пациенты ощущают болезненность лимфатических узлов в области укуса. В некоторых случаях наблюдается дискомфорт в глазах. В месте проникновения инфекции могут образовываться язвы, которые вскоре прорываются с выделением гноя. При употреблении зараженного мяса возможен водянистый понос и сильные боли в области ребер. Упоминание еды может вызывать рвоту. При воздушно-капельном заражении пациенты жалуются на сильную боль в груди, кашель и одышку.
Опрос пациента
Цель опроса — выяснить начало заболевания. Врач задает вопросы о времени появления симптомов и их особенностях, обращая внимание на динамику проявлений. Также определяется возможный источник инфекции и способ заражения. Ответы помогают установить диагноз, определить сроки инкубационного периода и предотвратить распространение туляремии.
Вопросы для сбора эпидемиологического анамнеза могут включать:
- наличие аналогичных симптомов у соседей, коллег или членов семьи;
- участие в охоте, рыбалке или туристических походах;
- поездки за границу;
- укусы животных или насекомых;
- профессиональная деятельность пациента;
- участие в забое скота или разделке животных;
- соответствие санитарным нормам условий работы или проживания;
- употребление некипяченой воды, сырого молока, недостаточно прожаренного мяса, немытых фруктов и овощей.
Физикальный осмотр
Во время осмотра врач исследует состояние кожи, глазные склеры и ротовую полость, проводит пальпацию живота и общий осмотр. Анализируя внешние признаки туляремии, врач делает выводы о форме и других аспектах заболевания.
К внешним симптомам туляремии относятся:
- увеличенные лимфатические узлы;
- покраснение глаз;
- воспаление слизистой горла;
- увеличение печени и селезенки (при редкой тифоидной форме);
- хрипы и ослабленные дыхательные шумы (при туляремической пневмонии);
- гиперемия кожи в области лимфатических узлов;
- сыпь на коже в виде мелких кровоизлияний;
- отекшее и припухшее лицо;
- синюшно-багровый оттенок лица;
- кровоизлияния в виде точек на слизистой рта.
Основным проявлением туляремии являются воспалительные папулы (плотные образования на коже). Этот признак характерен для локальных форм заболевания. Папулы могут образовываться на руках, подмышечных впадинах, глазах и небе. Вскоре они заполняются гноем и прорываются, образуя язвенный кратер.
Лабораторные исследования
Лабораторная диагностика туляремии включает несколько методов. Учитывая разнообразие клинической картины, эти методы важны для выявления заболевания. Для анализа используются гной из бубонов, мокрота или кровь.
Методы лабораторного исследования туляремии:
- аллергический метод;
- серологические методы;
- бактериологические методы.
Аллергический метод
Метод включает кожные тесты, проводимые в первую неделю заболевания. Эти тесты специфичны для ранней диагностики туляремии и основаны на местной аллергической реакции, вызванной возбудителем болезни.
Тест заключается во внутрикожном введении тулярина и наблюдении за кожной реакцией. Тулярин — биопрепарат из убитых бактерий туляремии, который наносят на кожу предплечья с помощью скарификационного метода. Через 24-48 часов на месте введения появляется покраснение и уплотнение (инфильтрат). Если инфильтрат превышает 5 мм, реакция считается положительной, что указывает на наличие туляремии. Положительная реакция может также наблюдаться у вакцинированных или переболевших, сохраняясь несколько лет.
Преимущества метода — высокая специфичность, простота и быстрота выполнения, а также возможность получения положительного результата на 3-5 день заболевания.
Серологические методы
Эти методы основаны на взаимодействии антигенов и антител. Антитела — белки, вырабатываемые иммунной системой в ответ на чуждые бактерии. Антигены — структуры бактерий, вызывающие иммунный ответ. В случае туляремии антигенами являются липополисахариды, капсулы и белки. При взаимодействии антител и антигенов образуется комплекс, который можно воспроизвести в лаборатории (in-vitro).
Наиболее часто применяется реакция агглютинации (РА), визуально проявляющаяся в виде хлопьев или осадка, представляющих собой склеенные бактерии туляремии и антитела.
Для реакции берут 3 мл крови пациента, выделяя сыворотку (в ней содержатся антитела). В качестве антигена используется туляремийный диагностик с миллиардами микробов туляремии. Реакцию проводят как на стекле (ориентировочная реакция), так и в пробирке (развернутая реакция).
Сначала на стекле смешивают каплю сыворотки и туляремийного диагностик. Если образуется осадок в виде хлопьев, реакция положительная. Если хлопья не появляются, реакция отрицательная, и пациент не болен туляремией. Этот быстрый вариант используется в экспресс-диагностике, затем проводится более детальная развернутая реакция в пробирке.
Еще одной чувствительной реакцией является реакция непрямой гемагглютинации (РПГА), основанная на том же принципе, но антигены прикрепляются к поверхности эритроцитов. Образование комплекса антитело+антиген+эритроцит приводит к склеиванию и выпадению эритроцитов в осадок.
Реакция проводится в планшетах-лунках или пробирках. При положительной реакции на дне пробирки образуется фестончатый осадок. При отрицательной реакции эритроциты не склеиваются и оседают на дно пробирки.
Бактериологические и биологические методы
Эти методы основаны на выделении чистых культур бактерий на специализированные среды. Сначала выделить культуру туляремийных бактерий из биологического материала (крови или мокроты) не удается, поэтому применяют биологическую пробу. Материал, взятый у пациента, заражают лабораторных свинок, восприимчивых к туляремии. После заражения у животного берут кровь и засевают на специальные среды, обогащенные аминокислотами, глюкозой и желтком. Посевы помещают в термостат на 5 дней при 37 градусах Цельсия. Колонии туляремийных бактерий образуются в виде капель, напоминающих росу. Если посев проводился на жидкую среду, она мутнеет, а на дне образуется осадок.
Метод также используется для исследования воды, пищевых продуктов и смывов на наличие возбудителя туляремии.
Лечение туляремии
Детоксикация организма
Детоксикация организма важна для лечения туляремии и направлена на удаление токсинов и бактерий. Для этого используются коллоидные растворы с витаминами группы В и сорбенты, которые связывают токсины. Применяется также форсированный диурез для стимуляции мочевыделения.
Препараты для детоксикации
| Название препарата | Механизм действия | Способ применения |
| Реамберин | Снижает уровень свободных радикалов, восстанавливает энергетические процессы, устраняет кислородное голодание клеток и восстанавливает кислотно-щелочной баланс. | Суточная доза для взрослых — 500–800 мл, вводится внутривенно капельно со скоростью 1 мл в минуту. |
| Поливедон | Связывает токсины и выводит их через почки, увеличивает почечный кровоток и мочевыделение. | Разовая доза — 200–400 мл, вводится внутривенно капельно со скоростью 40 капель в минуту, перед введением подогревается до температуры тела. |
| Венофундин | Увеличивает объем циркулирующей крови, улучшая гемодинамические показатели, особенно при низком артериальном давлении. | Суточная доза — 250–500 мл, вводится медленно под наблюдением. |
| Витамин С | Устраняет кислородное голодание и подавляет воспалительные процессы. | В остром периоде вводится внутривенно с капельницами, затем можно перейти на внутримышечное введение по одной ампуле в течение 7 дней. |
| Пиридоксин (витамин В6) | Стимулирует обменные процессы, особенно в миокарде, и усиливает энергетические процессы в нервной ткани. Важен при генерализованных формах туляремии. | Применяется внутривенно или внутримышечно по 50–150 мг (1–3 ампулы) в сутки в течение 10–14 дней. |
| 20-процентный раствор глюкозы + фуросемид (метод форсированного диуреза) | Глюкоза увеличивает объем циркулирующей жидкости, фуросемид способствует выведению жидкости через почки, удаляя токсины. | 800 мл глюкозы вводят внутривенно, через час вводят 40 мг (одна ампула) фуросемида. |
Лечение антибиотиками
Антибиотикотерапия — ключевой элемент лечения туляремии. Применяются аминогликозиды, такие как стрептомицин и гентамицин, а также тетрациклины, включая тетрациклин и доксициклин.
Антибиотики, применяемые при туляремии
| Название препарата | Механизм действия | Способ применения |
| Стрептомицин | Проникает в бактерии, связывается с рибосомами, нарушая синтез белков. | Вводится внутримышечно: 500 мг дважды в день при локальных формах, 1 грамм дважды в день при легочной и абдоминальной формах. |
| Гентамицин | Вводится внутримышечно: 80 мг дважды в день при локальных формах, 80 мг четыре раза в день при поражении внутренних органов. | |
| Доксициклин | Блокирует синтез белков, что приводит к гибели клеток. | Принимается внутрь по 100 мг (одна таблетка) дважды в день. |
| Тетрациклин | Принимается внутрь по 500 мг четыре раза в сутки. |
Вакцинация от туляремии
Вакцинация против туляремии предотвращает заражение бактериями и развитие заболевания, особенно в регионах с высоким риском инфицирования. Рекомендуется для всех возрастных групп, начиная с семилетних детей.
Когда проводится вакцинация?
Вакцинация зависит от эпидемиологических условий в природных очагах инфекции. В некоторых случаях охватывает всё население региона, кроме детей младше 7 лет и лиц с противопоказаниями.
Условия для вакцинации всего населения от туляремии:
- зарегистрированные случаи туляремии в районе в прошлом;
- зарегистрированные случаи туляремии в соседних районах;
- подтвержденное присутствие возбудителя туляремии в животных и окружающей среде.
Если нет эпидемиологических показаний, вакцинация проводится только для определенных групп.
Группы для плановой вакцинации в неэпидемиологических зонах:
- работники сельского хозяйства, связанные с зерновыми и овощными культурами (например, сотрудники хранилищ, мельниц);
- работники, занимающиеся скотом и домашней птицей (например, фермеры, сотрудники мясокомбинатов);
- дератизаторы и дезинсекторы;
- работники санитарно-противоэпидемической службы;
- лица, временно работающие в эпидемических районах (например, для покоса, рыбалки, охоты);
- лица, занимающиеся заготовкой шкурок грызунов;
- сотрудники меховых фабрик;
- работники лесного хозяйства;
- лабораторный персонал, работающий с культурами бактерий туляремии.
При резком увеличении численности грызунов и выявлении туляремии среди животных проводится экстренная вакцинация, в первую очередь для работников сельского хозяйства. При регистрации случаев туляремии среди людей вакцинация всего населения осуществляется быстро. В особо опасных очагах прививка может быть назначена детям с двух лет.
Что входит в состав вакцины?
Вакцина содержит живые ослабленные бактерии туляремии с низкой реактогенностью. Бактерии культивируются в лаборатории, высушиваются и превращаются в лиофилизат. Для вакцинации лиофилизат растворяется в дистиллированной воде и наносится на кожу или вводится подкожно.
Способы введения вакцины от туляремии
| Накожный метод | Подкожный метод | |
| Доза препарата | 2 капли раствора (около 200 миллионов бактерий). | 0,1 миллилитр раствора (около 10 миллионов бактерий). |
| Место введения | Средняя треть плеча. | Средняя треть плеча. |
| Техника выполнения | * Обработка кожи этанолом; * нанесение двух капель вакцины на расстоянии 30-40 мм; * натяжение кожи и насечки на расстоянии 10 мм; * втирание капель вакцины в насечки; * оставление кожи просохнуть на 5-10 минут. | * Обработка кожи этанолом; * вакцина вводится с помощью инъектора, соприкасающегося с кожей. |
Какова эффективность вакцинации?
Эффективность вакцинации высокая. Введение ослабленных бактерий способствует образованию специфических антител. Полное формирование иммунитета происходит через 20-30 дней. Стойкий иммунитет сохраняется до пяти лет, после чего возможна ревакцинация.
Реакции и противопоказания к вакцинации
Местная реакция должна проявляться у всех вакцинированных. При накожном методе возможны покраснения и отек на месте насечек, которые проходят через 10-15 дней. При подкожной вакцинации могут возникать припухлость и покраснение, общее недомогание, головная боль и повышенная температура. Реакция может быть более выраженной у тех, кто перенес туляремию. Перед вакцинацией проводится опрос и осмотр для выявления противопоказаний.
Противопоказания для вакцинации:
- обострения хронических заболеваний;
- острые инфекции;
- иммунодефицит;
- злокачественные заболевания крови;
- предрасположенность к аллергии;
- беременность и период грудного вскармливания.
Хирургическое удаление или вскрытие нагноившихся бубонов
Вскрытие нагноившихся бубонов происходит редко, так как в большинстве случаев они самостоятельно прорываются, и гной изливается из раны. В этом случае достаточно обработать рану антисептиком и наложить повязку с тетрациклиновой или стрептомициновой мазью.
Если бубон не вскрывается, требуется хирургическое вмешательство. Процедура проводится под местной анестезией, что делает её безболезненной.
Техника проведения
Хирургическая процедура должна выполняться в стерильных условиях. Кожу над бубоном обрабатывают раствором йода несколько раз. Затем делают широкий разрез скальпелем. После разреза гной вытекает, его необходимо максимально удалить, чтобы избежать повторного нагноения. Излившийся гной подлежит бактериологическому и биологическому исследованию. Образовавшуюся полость обрабатывают антисептиком и накладывают повязку с мазью. Рекомендуется периодически менять повязку и наносить антибактериальную мазь на рану.
Профилактика туляремии
Профилактика туляремии заключается в минимизации контактов с возможными носителями инфекции. Необходимо соблюдать меры предосторожности и правила личной гигиены, особенно в зонах с высоким риском заражения. Находиться в потенциальных очагах туляремии можно как в профессиональной деятельности, так и в повседневной жизни.
Для предотвращения заболевания рекомендуется:
- соблюдать меры предосторожности во время отдыха на природе;
- следовать правилам безопасности при работе в саду или огороде;
- учитывать рекомендации при взаимодействии с животными;
- проходить вакцинацию.
Людям с профессиями, связанными с повышенным риском, следует строго придерживаться этих рекомендаций для защиты от туляремии.
Меры предосторожности на природе
В естественной среде есть территории с повышенным риском туляремии. Инфицирование может произойти во время охоты, рыбалки, туристических походов или активного отдыха.
К источникам инфекции в дикой природе относятся:
- клещи;
- комары;
- слепни;
- златоглазки;
- блохи;
- водяные крысы;
- ондатры;
- зайцы;
- лисы.
Распространение возбудителей туляремии зависит от типа местности и времени года. Наибольшая вероятность заражения наблюдается в конце весны, летом и в начале осени.
Территории, где обитают переносчики инфекции:
- болота;
- районы рядом с горными и предгорными ручьями;
- поймы рек;
- озера;
- поля;
- луга;
- степи;
- леса.
Для снижения риска контакта с переносчиками важно носить специальную одежду и обрабатывать кожу и вещи защитными средствами. Рекомендуется тщательно выбирать места для стоянок и ночлега, соблюдать личную гигиену и избегать употребления воды из непроверенных источников.
Средства, отпугивающие насекомых
Средства защиты от насекомых имеют разные характеристики. При выборе важно учитывать условия использования и продолжительность действия.
Основные характеристики средств против насекомых:
- способ воздействия;
- форма выпуска;
- тип применения.
Способы воздействия защитных средств
Продукция для борьбы с насекомыми делится на несколько категорий. Основные виды: репелленты, акарицидные средства и комбинированные препараты.
Репелленты содержат активное вещество (диэтилтолуамид), отпугивающее насекомых запахом. Наносятся на одежду и открытые участки кожи (запястья, щиколотки). Существуют препараты для детей (менее токсичные) и высокотоксичные, которые не рекомендуется наносить на кожу. Информация о применении указана на упаковке. Репелленты наиболее эффективны против комаров.
К репеллентам относятся:
- рефтамид максимум;
- бибан;
- дэта-ВОККО;
- галл-РЭТ;
- фталар;
- эфкалат.
Акарицидные средства содержат активное вещество (альфаметрин), вызывающее паралич насекомых. Эти препараты предназначены только для обработки одежды из-за высокой токсичности. Альфаметрин вызывает паралич конечностей у насекомых, что приводит к их падению. Используются для защиты от клещей.
К акарицидным препаратам относятся:
- рефтамид таежный;
- пикник антиклещ;
- гардекс аэрозоль экстрим;
- претикс.
Комбинированные препараты содержат два активных вещества и защищают как от клещей, так и от летающих насекомых. Наносятся только на одежду.
К комбинированным средствам защиты относятся:
- медилис-комфорт;
- москитол-спрей;
- клещ-капут;
- гардекс экстрим.
Форма выпуска отпугивающих препаратов
Продукция для защиты от насекомых доступна в различных формах: аэрозоли, лосьоны, кремы и карандаши. Также есть отпугивающие браслеты. Некоторые препараты защищают от комаров, клещей и солнечных лучей. Аэрозольная форма удобна в использовании, но часто имеет меньшую продолжительность действия.
Тип использования
Средства для отпугивания насекомых могут быть индивидуального или коллективного применения. К групповым относятся свечи, фумигаторы и ловушки. Эти средства служат дополнительной защитой, но не являются высокоэффективными в профилактике туляремии.
Правила использования защитных средств
Для повышения эффективности и минимизации побочных эффектов следует соблюдать несколько правил.
Основные правила применения средств защиты от насекомых:
- проверяйте срок годности и наличие лицензии при покупке;
- обновляйте препарат по истечении срока действия, указанного на упаковке;
- активное потоотделение сокращает срок действия средств на коже;
- время действия препаратов на одежде уменьшается при дожде и ветре.
Одежда для профилактики туляремии в природных условиях
При посещении мест с высоким риском туляремии важно носить защитную одежду. Даже в теплую погоду стоит выбирать брюки и кофты с длинными рукавами, а воротники и манжеты должны плотно прилегать к телу. Рекомендуются головные уборы, такие как кепки или косынки. Обувь должна быть представлена сапогами или ботинками с высокими носками.
Лучший вариант — специальный костюм против клещей, который сочетает механические и химические методы защиты. На таких изделиях размещены ловушки для насекомых, уничтожающие переносчиков заболеваний.
Во время туристических походов следует внимательно выбирать место для стоянки. Не устанавливайте палатки рядом с норами животных, которые могут быть переносчиками инфекции, и избегайте зарослей бурьяна, где могут обитать инфицированные грызуны. Периодически проверяйте тело и одежду на наличие клещей. У взрослых клещи чаще всего кусают ноги, область гениталий и ягодицы, а у детей — волосистую часть головы.
Профилактические меры по предотвращению туляремии включают:
- Вся вода для питья и хозяйственных нужд должна кипятиться.
- После контакта с животными тщательно мойте руки с мылом.
- При разделке туш животных на охоте обрабатывайте руки дезинфицирующим средством.
- Не употребляйте сырое или полусырое мясо, так как в нем могут быть патогенные бактерии.
- Вся пища, приготовленная на природе, должна быть хорошо прожарена или доведена до кипения.
- Не собирайте грибы или ягоды с признаками помета птиц или грызунов.
- Продукты и напитки храните в плотно закрывающейся таре.
Также обеспечьте защиту от клещей и насекомых для домашних животных, если они с вами в походе. Используйте спреи, ошейники и другие средства, доступные в ветеринарных магазинах. Не оставляйте животных без присмотра и не позволяйте им приближаться к трупам других животных или купаться в водоемах с запрещающими знаками.
Меры предосторожности при садово-почвенных работах
При работе в саду или огороде рекомендуется использовать респираторы или ватно-марлевые повязки для защиты от заражения через воздух и пыль. Обязательно надевайте перчатки и высокую обувь. В помещениях, долго не использовавшихся, проведите влажную уборку с дезинфицирующими средствами. На садовых участках поддерживайте порядок, а бытовые и пищевые отходы храните в контейнерах с плотно закрывающимися крышками. Для предотвращения появления грызунов уничтожайте заросли сорняков и используйте капканы или отравленные приманки.
Профилактика туляремии при работе с животными
Тем, кто разводит животных, важно соблюдать меры предосторожности, чтобы избежать заражения. Бактерии могут находиться в экскрементах, шерсти и других продуктах жизнедеятельности.
Среди сельскохозяйственных животных, подверженных туляремии, выделяются:
- кролики;
- нутрии;
- поросята;
- ягнята;
- цыплята.
Заражение туляремией может произойти при уборке помещений, кормлении или разделке туш. Для снижения риска инфицирования все работы следует выполнять в перчатках, защитных масках, очках и фартуках. После контакта с животными необходимо тщательно мыть руки с мылом и обрабатывать их дезинфицирующим средством.
Группы профессионального риска
Организации, занимающиеся разведением животных и переработкой сельскохозяйственной продукции, имеют повышенный риск заражения туляремией.
К специальностям с высоким риском заражения относятся:
- пастухи;
- рыболовы и охотники;
- работники служб по отлову бездомных животных;
- сотрудники мясоперерабатывающих заводов и животноводческих ферм;
- лица, занимающиеся благоустройством лесных территорий;
- специалисты по заготовке и переработке сельскохозяйственных товаров.
Руководители таких предприятий обязаны организовывать мероприятия по уничтожению грызунов на своих территориях. Здания и прилегающие участки должны быть защищены от проникновения мышей и крыс. В радиусе 200 метров необходимо очищать участки от мусора и сухих растений. Также руководители должны обеспечивать сотрудников средствами индивидуальной защиты от насекомых и проводить обучение по профилактическим методам.
Вопрос-ответ
Каковы симптомы туляремии?
У больного начинаются сильные головные боли и рвота. Характерными признаками тяжелого течения туляремии считаются отечность и синюшно-багровый цвет лица (особенно мочек ушей, век и губ), покраснение белков глаз с возможным развитием конъюнктивита, носовые кровотечения.
Где можно заразиться туляремией?
Характерные для туляремии пути передачи: трансмиссивный – при укусах комаров, клещей, слепней; контактно-бытовой – при соприкосновении с больными грызунами или их выделениями, а также с трупами павших животных; пищевой – при употреблении загрязненных выделениями грызунов пищевых продуктов и воды.
От чего делают туляремию?
Длительное и тяжелое течение, медленное выздоровление, а также возможная инвалидизация обуславливают актуальность этой инфекции. Источниками туляремии являются водяные крысы, ондатры, зайцы, все виды полевок и мышей. Большую роль, как хранители и переносчики туляремийной инфекции, играют иксодовые клещи.
Что является возбудителем туляремии?
Возбудитель туляремии — мелкая грамотрицательная коккобактерия Francisella tularensis — относится к семейству Francisellaceae, роду Francisella. На территории Российской Федерации распространен голарктический подвид, резервуаром которого в природе, преимущественно, являются грызуны и зайцеобразные.
Советы
СОВЕТ №1
Обратите внимание на симптомы. Туляремия может проявляться различными симптомами, такими как высокая температура, увеличение лимфатических узлов и кожные высыпания. Если вы заметили у себя или у близких подобные признаки, не откладывайте визит к врачу.
СОВЕТ №2
Изучите факторы риска. Туляремия чаще всего встречается у людей, работающих с животными или в сельском хозяйстве. Если вы относитесь к этой группе, соблюдайте меры предосторожности, такие как использование защитной одежды и соблюдение гигиенических норм.
СОВЕТ №3
Не игнорируйте профилактические меры. Вакцинация и соблюдение санитарных норм могут помочь снизить риск заражения туляремией. Убедитесь, что у вас есть актуальная информация о вакцинации и профилактических мерах в вашем регионе.
СОВЕТ №4
Своевременно проходите медицинские обследования. Регулярные медицинские осмотры помогут выявить заболевания на ранней стадии. Если вы находитесь в зоне риска, обсудите с врачом необходимость дополнительных анализов и обследований.